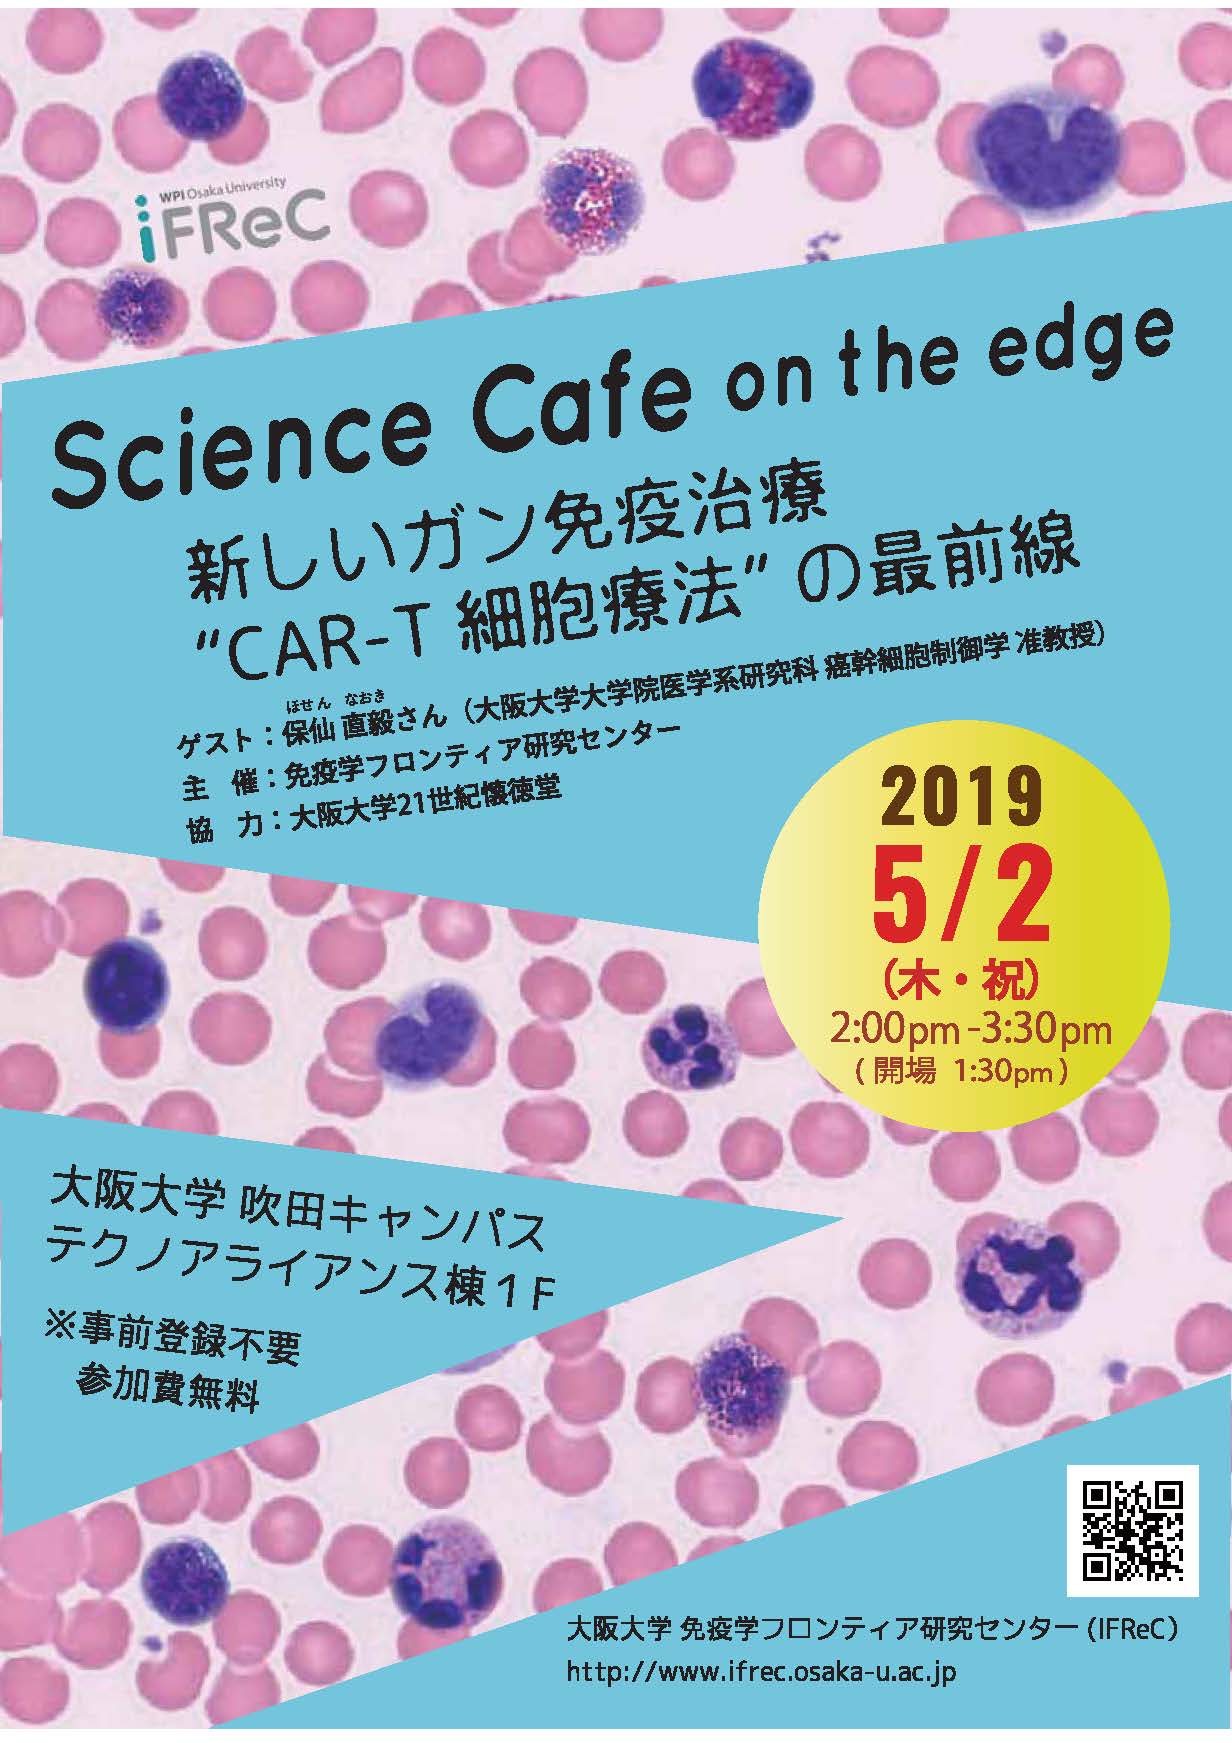
サイエンスカフェ・オンザエッジ@いちょう祭「新しいガン免疫治療“CAR-T細胞療法”の最前線 」

For You
For Youを見る
Events
サイエンスカフェ・オンザエッジ@いちょう祭「新しいガン免疫治療“CAR-T細胞療法”の最前線 」
対象 |
|
|---|---|
日時 | 2019.5.2 Thu 14:00 - 15:30 |
ゲスト
保仙 直毅さん(大阪大学 医学系研究科 癌幹細胞制御学 准教授)
ファシリテーター
渡部 祐司(大阪大学 免疫学フロンティア研究センター 企画室)
サイエンスカフェ・オンザエッジとは?
IFReCや関連研究分野の研究者をゲスト(話題提供者)に迎え、最先端の研究内容を一般の方にもわかりやすく紹介します。最新の研究をもとに話題を提供し、皆さんと一緒に科学について対話することで、科学をより身近に感じて欲しい『サイエンスカフェシリーズ』です。
プログラム
13:30~14:00 開場
14:00~15:30 話題提供&質疑応答
※事前登録不要 / 参加費無料(お飲み物をご用意しています。お気軽にお立ち寄りください。)
share !